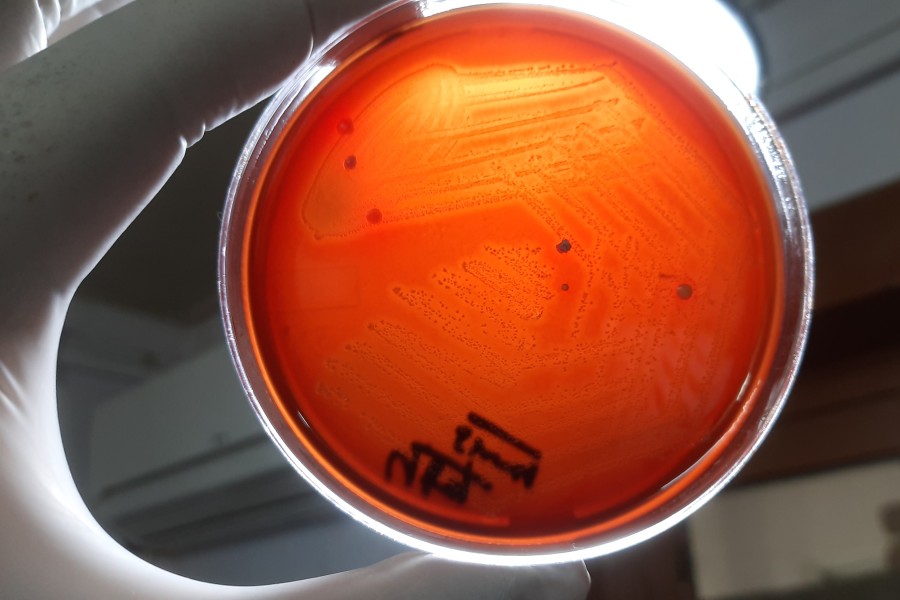

/Fuente: Federación Bioquímica de la Provincia de Buenos Aires FABAInforma/
Argentina, el primer país de la región en comunicar datos genómicos referidos a la reemergencia de infecciones graves por Streptococcus pyogenes. La vigilancia genómica, una metodología clave para detectar variantes o linajes hipervirulentos y anticipar brotes.
Por Ana M. Pertierra
La Sociedad Europea de Microbiología Clínica y Enfermedades Infecciosas otorgó una beca a la Lic. Lucía Cipolla, del Laboratorio Nacional de Referencia Bacteriología Especial de la ANLIS-Malbrán, para presentar los resultados de vigilancia genómica del Streptococcus pyogenes en la Mesa Internacional de Genómica en Vigilancia de Patógenos, que se llevó a cabo en el Congreso Internacional ESCMID 2025 que tuvo lugar en Viena, del 11 al 15 de abril, un encuentro que reúne a expertos del Reino Unido, Suiza, Países Bajos, Italia y Portugal. Este reconocimiento para la investigadora argentina representa un hito para la ciencia nacional y refleja la excelencia técnica del país y su contribución al avance científico global.

Lic. Lucía Cipolla, Biotecnóloga y Magister en Microbiología Molecular del Servicio de Bacteriología Especial -INEI-ANLIS- Malbrán
FABAinforma se comunicó con Lucía Cipolla, Licenciada en Biotecnología de la Universidad Nacional de Quilmes , Magister en Microbiología Molecular (UNSAM), y Profesional Principal del Servicio Bacteriología Especial – Departamento de Bacteriología – Instituto Nacional de Enfermedades Infecciosas – ANLIS “Dr. CG Malbran”. Como investigadora, se dedica a la epidemiología molecular y genómica aplicada a salud pública, y la taxogenómica de patógenos bacterianos emergentes e inusuales. Reconocida recientemente por su labor con el otorgamiento de una beca para asistir a presentar su trabajo en el Congreso Internacional ESCMID 2025, la especialista comentó su experiencia en dicho encuentro y dio detalles de la importancia clave de los estudios genómicos para para anticipar brotes de variantes hipervirulentas de S. pyogenes.
¿Qué significa para usted en particular y para el ANLIS y por ende para nuestro país haber participado en el Congreso de la Sociedad Europea de Microbiología Clínica y Enfermedades Infecciosas (ESCMID 2025)?
Participar en ESCMID 2025 representó, a nivel personal, un orgullo, una gran oportunidad de crecimiento profesional y una posibilidad de escuchar a referentes internacionales en microbiología clínica y enfermedades infecciosas. Creo que para ANLIS, es un reconocimiento al trabajo científico que se realiza en nuestra institución y una posibilidad de mostrar nuestro trabajo y posicionarnos como referentes en este tema a nivel global.

¿Qué trabajo presentó y cuál fue su repercusión en este evento científico que se llevó a cabo en Viena del 11 al 15 de abril?
Nuestro trabajo, sobre la vigilancia genómica de Streptococcus pyogenes invasivo en Argentina realizado durante el año 2023, fue seleccionado para presentación oral en el ESCMID. El trabajo despertó interés porque somos el primer país de la región en mostrar datos genómicos y profundizar en la dinámica local de la reemergencia de infecciones graves por S. pyogenes pos pandemia, en concordancia con lo observado en otros países de Norteamérica y Europa. El impacto fue tal que, además de la selección para presentación oral, recibí una beca para poder asistir al Congreso.
¿Qué es la vigilancia genómica y cuál es su importancia sanitaria?
La vigilancia genómica es una herramienta fundamental para el monitoreo de S. pyogenes, ya que permite detectar mutaciones y la adquisición de factores de virulencia o genes de resistencia a los antimicrobianos en su contenido genético. Estos cambios pueden dar origen a lo que se conoce para S. pyogenes como variantes o linajes hipervirulentos, que pueden emerger en otros países o incluso en el nuestro, y que con otra metodología no podrían detectarse.

Su importancia sanitaria es crucial, ya que puede ayudar a anticipar brotes, emitir alertas, entender mejor la dinámica poblacional de este microorganismo y conocer la cobertura de una potencial vacuna para este microorganismo, cuyo desarrollo es una prioridad para la OMS.
Además, haber implementado este tipo de vigilancia para este microorganismo nos equipara a los sistemas de vigilancia más robustos a nivel mundial.
¿Cuál es su diferencia respecto a la vigilancia epidemiológica?
La vigilancia genómica complementa a la vigilancia epidemiológica y es la metodología que permite comprender la dinámica y evolución de este microorganismo. S. pyogenes es un patógeno de alto impacto en salud pública por la carga de enfermedad que produce en el mundo. De hecho es un patógeno prioritario para la OMS. Sin este tipo de vigilancia no podríamos detectar los linajes emergentes, más virulentos y/o resistentes.
¿Qué rol tuvo y tiene el programa de vigilancia genómica de Streptococcus pyogenes a través del Instituto Nacional de Enfermedades Infecciosas (INEI), dependiente de ANLIS, en la detección del ingreso de variantes hipervirulentas al país implementado en 2022?
La decisión sanitaria de incorporar, durante el año 2022, los cuadros invasivos por S. pygenes dentro de las enfermedades de notificación obligatoria fue decisiva para la implementación de este programa de vigilancia genómica del INEI. Esto nos permitió identificar de manera temprana la circulación en Argentina de linajes hipervirulentos, observar su evolución en el tiempo y establecer su impacto clínico y epidemiológico. Gracias a esta información, pudimos emitir alertas y fortalecer la vigilancia a través de los boletines epidemiológicos.
También quiero destacar la participación de todos los laboratorios públicos y privados que componen nuestro sistema de salud que han realizado las derivaciones de los aislamientos a nuestro laboratorio, que sin su colaboración, esto no hubiese sido posible.
¿Cómo calificaría el nivel de la ciencia argentina, en particular el aplicado a la salud de la población?
Personalmente, como alguien que forma parte del sistema y habiendo tenido la oportunidad de participar en este evento, creo que el nivel de la ciencia argentina en salud es de excelencia y altamente competitivo, incluso en contextos de recursos limitados. En particular, nuestra institución, el INEI, tiene una tradición de investigación científica, y desde todos los servicios que la componemos se muestra una gran capacidad de innovación, resiliencia y compromiso para la mejora de la salud pública. La ciencia aplicada a salud en nuestro país no sólo produce conocimiento, sino que tiene impacto y es reconocida de manera concreta por organismos internacionales.